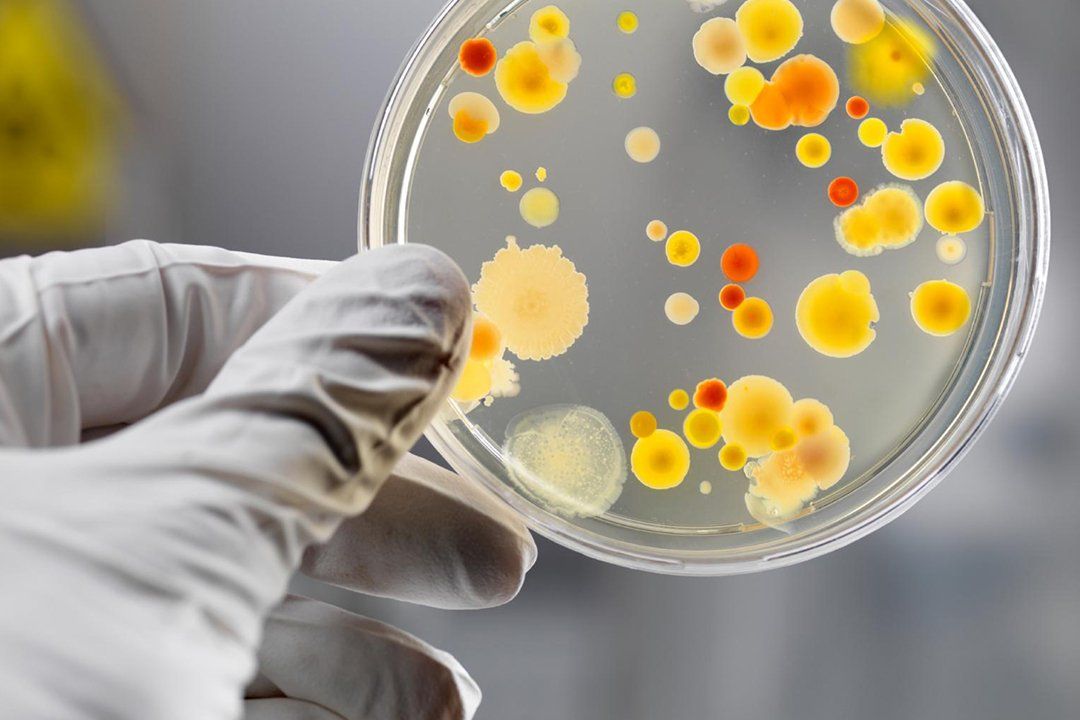

SCABA LABORATÓRIO
A
SCABA
Laboratório é
responsável pelos
serviços de
monitoramentos das matrizes
ambientais (águas, ar,
solo e acústica), gerando
resultados confiáveis
através de sua
relação
transparente e respeitosa para
com seus clientes.
Atendemos aos métodos
validados e certificados pelos
organismos nacionais (ABNT,
CETESB, FEPAM, IAP entre outros
órgãos estaduais)
e internacionais (Standard
Methods e EPA) para
realização das
atividades de
laboratório.
Dentre os serviços ofertados, destacam-se os monitoramentos atmosféricos (emissões atmosféricas de fontes fixas e qualidade do ar ambiente), análises de águas/efluentes, ruído externo ambiental e avaliação de agentes químicos e físicos inerentes a segurança do trabalho e higiene ocupacional.
Encaramos como prioridade em nossos objetivos atuar conforme os requisitos da ABNT NBR ISO/IEC 17025:2017.
A SCABA Laboratório é a parceira ideal em fornecer monitoramentos e soluções ambientais, por meio de um atendimento personalizado, facilitando a gestão dos efluentes industriais da sua empresa, e conta com os seguintes serviços:
- Análises físico-químicas:
Ecotoxicidade, Efluentes Líquidos e Água Potável.
- Poços de monitoramento/Águas Subterrâneas (BTEX, HPA TPH, Metais, etc.);
- Solo e Resíduos Sólidos;
- Ruído Ambiental;
- Estudos de Dispersão de Poluentes Atmosféricos;
- Emissões Atmosféricas, que incluem as análises de:
Gases de Combustão (%O2, %CO2, CO, NOx e SOx);
Material Particulado;
Compostos Orgânicos Voláteis (COV/VOC);
Amônia (NH3), Sulfato de Hidrogênio (H2S) e Hidrocarbonetos Totais (CxHy);
Substâncias Gasosas Inorgânicas (SGI).
- Qualidade do Ar Ambiente, que incluem as análises de:
Partículas Totais em Suspensão (PTS);
Partículas Inaláveis (MP10).